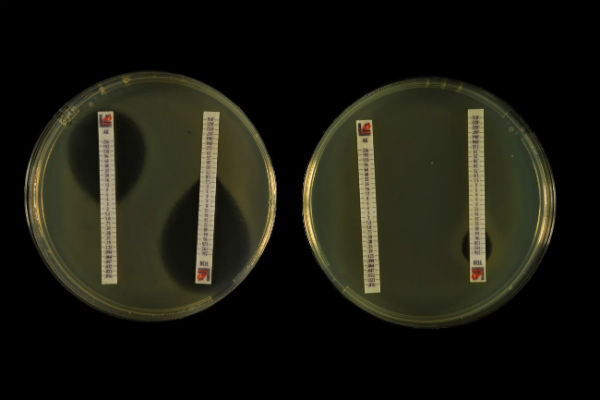

El método se basa en la comparación de la estructura tridimensional de las proteínas que causan la resistencia. Un primer análisis muestra que la resistencia de los microbios intestinales no se transmite a la especies patógenas con las que conviven
En la foto se muestra la inhibición del crecimiento bacteriano que producen los antibióticos. El tamaño de los halos indica si una bacteria es sensible o resistente. Izquierda, sensible; derecha, resistente. Imagen de Inés Poveda, Centro Nacional Biotecnología (CNB-CSIC).
La resistencia de los microbios a los antibióticos es uno de los mayores retos de la sociedad. Es crucial entender cómo se produce la resistencia frente a los antibióticos y cómo se transfieren entre diferentes patógenos. Ahora, un equipo internacional con participación de investigadores del Consejo Superior de Investigaciones Científicas (CSIC) ha desarrollado un nuevo método que permite predecir la resistencia de los microbios intestinales a los antibióticos, y cómo pueden transmitir su capacidad de resistencia a otras especies de microbios.
La nueva técnica, cuyos resultados se publican en la revista Nature Microbiology, se basa en la comparación de la estructura tridimensional de las proteínas que causan la resistencia. Sus resultados permitirán conocer mejor la composición genética de los microbios y también abren una vía para desarrollar proteínas de valor biotecnológico que pueden ser aplicadas en procesos industriales, a partir de datos de secuenciación de metagenomas.
“Este análisis amplía en gran medida el conocimiento de los genes de resistencia a los antibióticos presentes en las bacterias comensales humanas, las que se encuentran en los intestinos”, señala el investigador José Luis Martínez, del Centro Nacional de Biotecnología, del CSIC, que ha participado en este estudio, liderado por un consorcio de investigadores franceses, británicos, holandeses y españoles.
“Todas las bacterias contienen genes de resistencia a los antibióticos, lo que se ha denominado su resistoma intrínseco”, añade Martínez. Dado que las bacterias comensales humanas (que contribuyen en el proceso digestivo) pueden coexistir con bacterias patógenas, es importante saber si los genes de resistencia de las bacterias comensales se transfieren a dichos patógenos.
Esta nueva metodología caracteriza exhaustivamente los determinantes de resistencia antibiótica de la microbiota intestinal y su capacidad para transferir dicha resistencia a otras especies de microbios. El nuevo método permite establecer la función de proteínas (no solo aquellas implicadas en resistencia a los antibióticos) de las que solo se conoce su secuencia. El uso de tecnologías como las desarrolladas en el trabajo permitirá comprender mejor la fisiología de los distintos microbiomas.
“El estudio también muestra que estos genes no se han transferido de un modo significativo, al menos por el momento, a las bacterias patógenas”. Aun así –añade el investigador- es importante mantener esta línea de investigación para conocer cómo se produce la transferencia de resistencia a los antibióticos y cómo puede afectar dicha transferencia a la salud pública.
Reseñas bibliográficas:
Etienne Ruppé, Amine Ghozlane, Julien Tap, Nicolas Pons, Anne-Sophie Alvarez, Nicolas Maziers, Trinidad Cuesta, Sara Hernando-Amado, Irene Clares, Jose Luís Martínez,Teresa M. Coque, Fernando Baquero, Val F. Lanza, Luis Máiz, Tiphaine Goulenok, Victoire de Lastours, Nawal Amor, Bruno Fantin, Ingrid Wieder, Antoine Andremont,Willem van Schaik, Malbert Rogers, Xinglin Zhang, Rob J. L. Willems, Alexandre G. de Brevern, Jean-Michel Batto, Hervé M. Blottière, Pierre Léonard, Véronique Léjard, Aline Letur, Florence Levenez, Kevin Weiszer, Florence Haimet, Joël Doré, Sean P. Kennedy and S. Dusko Ehrlich. Prediction of the intestinal resistome by a three-dimensional structure-based method. Nature Microbiology. DOI: 10.1038/s41564-018-0292-6